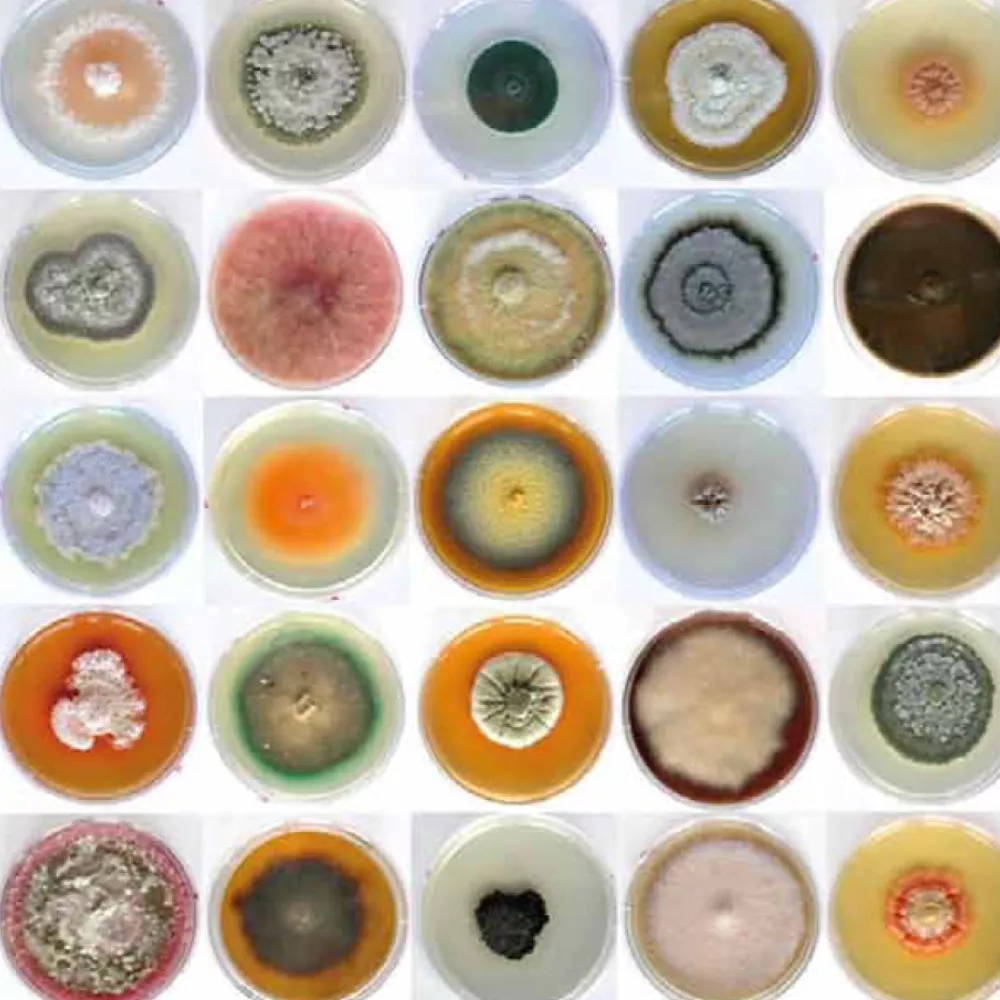
FOTCIENCIA7

Catalogue of the 7th Edition of FOTCIENCIA
Tipo de publicación
Comunicación científica
Año de edición
2009
For another year, art and science combine in this catalogue of the seventh edition of the FOTCIENCIA competition. This scientific photography contest, organised by the Spanish Foundation for Science and Technology (FECYT) and the Spanish National Research Council every year receives increasingly surprising and magical images taken by researchers in the course of their work, which show that these are two worlds with more similarities than differences, two worlds that complement each other. In this edition, more photographs were received than in the previous year (673) and, again, we were forced to make the difficult choice, given the great quality of the works, of selecting a small group of images to be included in this catalogue.